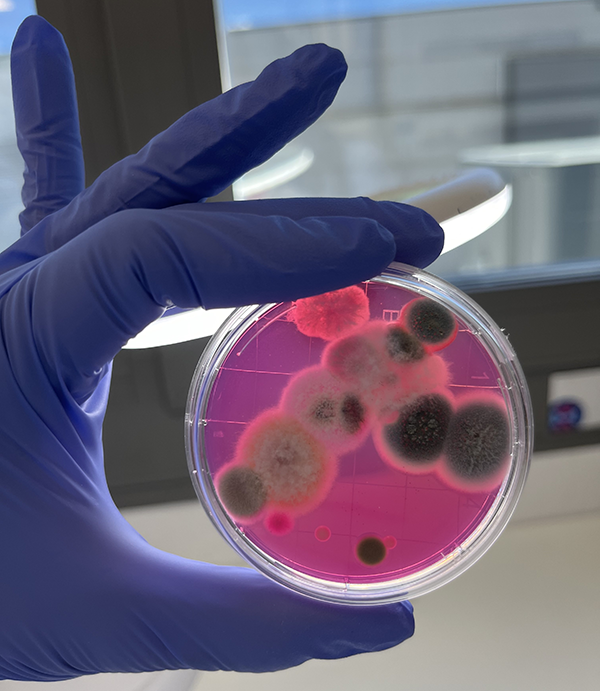
GRUPO AIRE LIMPIO adquiere un Laboratorio 3

El Grupo Aire Limpio ha adquirido, a través de su filial Ambisalud, el laboratorio Aire Interior S.L. especializado en la evaluación de la calidad del aire interior, con el objetivo de internalizar el control de este tipo de análisis y mejorar así su capacidad de servicio en la realización de inspecciones ambientales en edificios y hospitales.
El laboratorio, acreditado por ENAC desde 2019, está especializado en el análisis de microbiología e higiene medioambiental y prestará servicio también al resto de filiales de Grupo Aire Limpio -Aire Limpio, Ambisalud, Commtech y Acsos-. El sello de ENAC certifica que el laboratorio realiza su trabajo de acuerdo a normas internacionalmente aceptadas y dispone de la competencia técnica requerida.

Grupo Aire Limpio ha trasladado las instalaciones del Laboratorio a su Centro Logístico de Leganés, donde ahora disponen de un espacio ampliado de unos 100 m2, equipado adecuadamente para la realización de los análisis de muestras de aire y polvo, y diseñado con una ergonomía mejorada para los empleados. Además, gracias a su espacio escalable, las instalaciones podrán ampliarse en el futuro para realizar otros tipos de análisis, como los de aguas.
Análisis para el cumplimiento de la normativa RITE
“Actualmente realizamos análisis microbiológicos a partir de las muestras facilitadas por nuestros clientes”, explica Lenny Ramírez, microbióloga y directora técnica del Laboratorio, que añade que “sobre las muestras de aire realizamos, por ejemplo, recuentos de microorganismos aerobios mesófilos, mohos y levaduras e identificaciones de hongos patógenos, mientras que sobre las muestras de polvo realizamos análisis gravimétricos, entre otros. Estos resultados permiten indicar al cliente si la valoración de la muestra está o no dentro de los parámetros marcados por la normativa RITE”.
Además de las muestras tomadas en el interior de los conductos, también analizan otras tomadas en superficie, como camillas o mesas de instrumental, asociadas a entornos críticos como UCIs, quirófanos, etc. Para ello, las instalaciones se encuentran acondicionadas con campana de flujo laminar y áreas diferenciadas en función del tipo de análisis, lo que permite evitar riesgos de contaminación cruzada en las muestras.
Esta última adquisición se enmarca dentro de la estrategia de crecimiento del Grupo Aire Limpio, cuyo objetivo es incrementar la oferta y mejorar el servicio que presta a sus clientes. Al inicio de este año 2024, Grupo Aire Limpio también inauguró sus nuevas oficinas centrales renovadas en las que se duplicó el espacio, prestando especial atención a los entornos de reuniones dentro de un espacio flexible, diáfano y colaborativo diseñado para favorecer el bienestar físico y mental de sus trabajadores y visitantes.







 Acreditado por ENAC desde 2019, está especializado en el análisis de microbiología e higiene medioambiental
Acreditado por ENAC desde 2019, está especializado en el análisis de microbiología e higiene medioambiental







